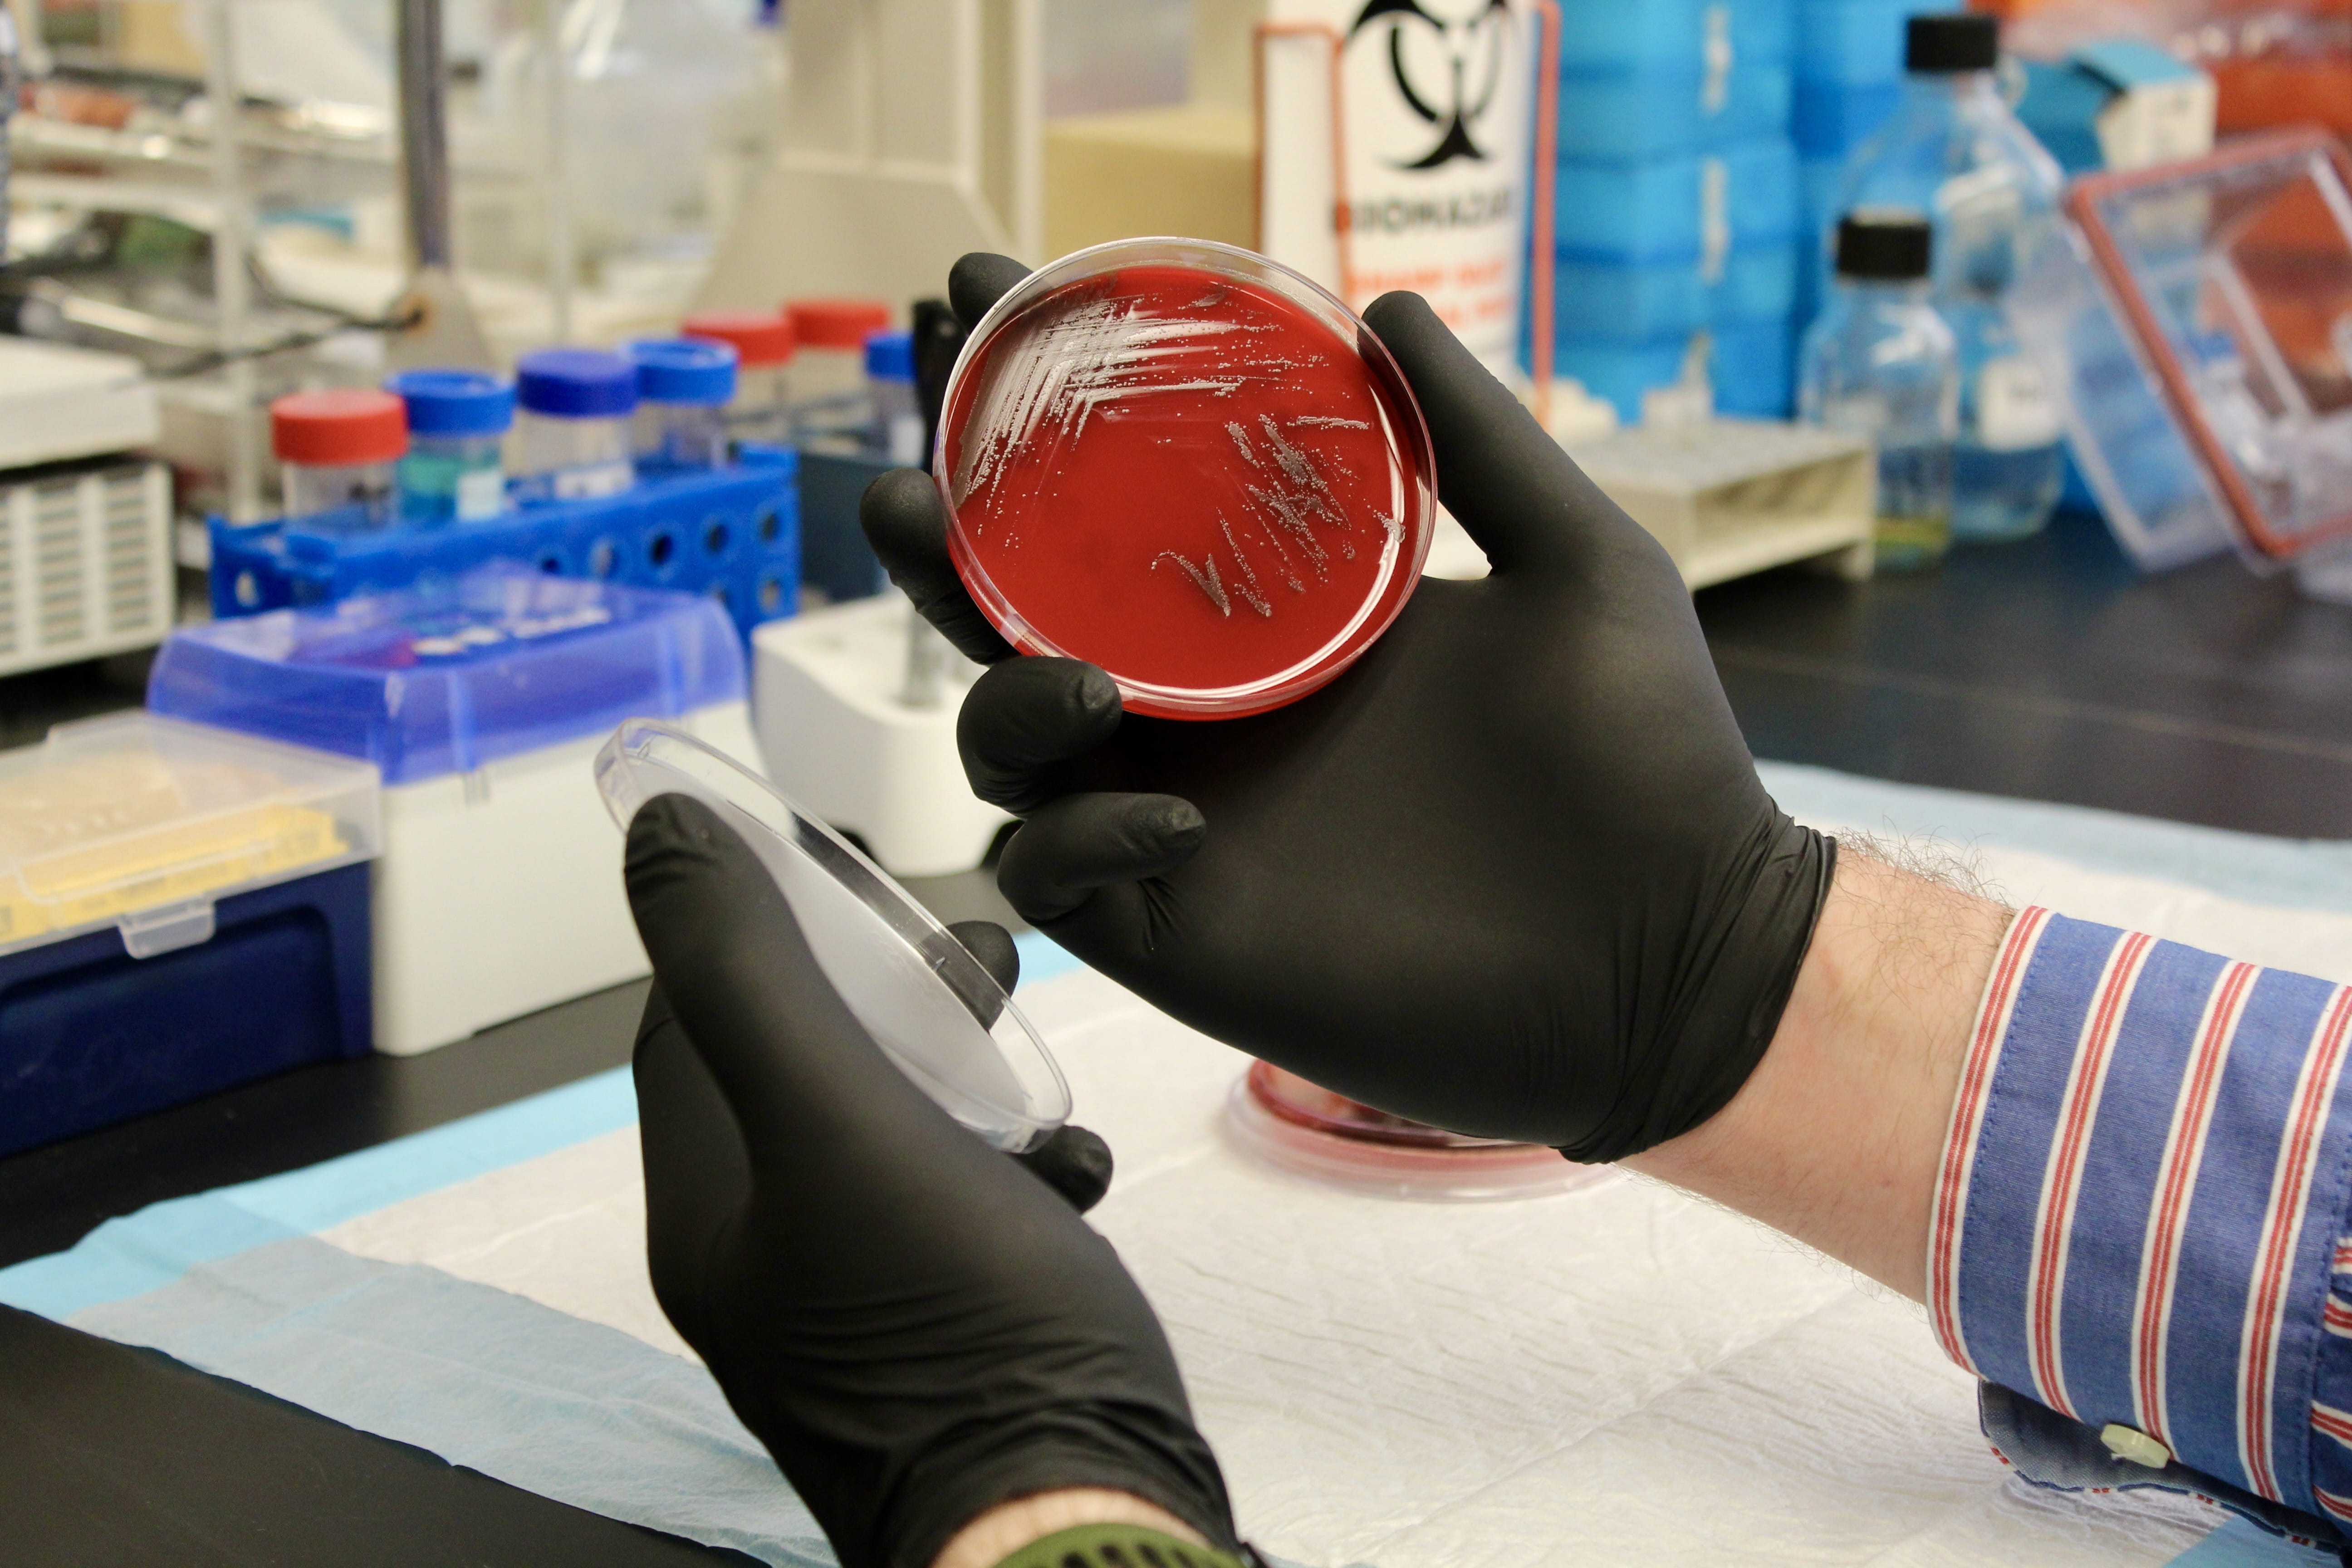

The Division of Infectious Diseases faculty at IU School of Medicine have an active research portfolio supported by NIH, CDC, foundations and industry. It includes basic science research in bacterial pathogenesis, HPV and malaria. Faculty investigators in this division also conduct prevention, treatment and implementation science research in HIV, other sexually transmitted infections, malaria and reproductive health infections.
Research Centers

Infectious Diseases Clinical Research Program
This team leads clinical trials to improve the health and well-being of Indiana adults and adolescents with a variety of infections.
Infectious Diseases Core Services Lab
This laboratory provides research support services for multiple investigators as well as clinical diagnostic services for multiple health care facilities studying sexually transmitted pathogens.
Global Health Research
Faculty investigators in the Department of Medicine’s Division of Infectious Diseases conduct critical global health research focused on improving population health, especially in resource-limited communities throughout the world. Explore IU School of Medicine’s global health education and research programs.